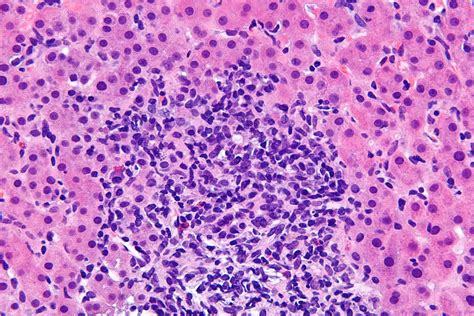
Соотношение аст и алт норма — Лечим печень

АЛТ и АСТ – одни из важнейших показателей в биохимическом анализе крови человека, напрямую указывающие на состояние внутренних органов. Превышение нормальных показателей свидетельствует о патологических процессах, происходящих в таких жизненно-важных органах, как сердце, печень, почки. Но особого внимания заслуживают показатели АЛТ и АСТ при гепатите, выявляющиеся в лабораториях.
Аминотрансферазы (трансаминазы) – внутриклеточные ферментные структуры, ускоряющие реакции трансаминирования.
Реакция трансаминирования – перенос аминогруппы (NH2) из аминокислоты на продукт обмена жиров – кетокислоту. Вследствие этого образуется новая аминокислота, синтезированная непосредственно в организме человека, и a-кетокислота. Активирует этот процесс витамин В6.

Трансаминазы присутствуют в каждой клетке человеческого тела, при нарушении целостности клеточных структур эти ферменты попадают в кровь.
В норме аминотрансферазы содержатся в крови по причине наличия запрограммированной смерти клеток – апоптоза. Это является нормой.
Однако, при массовой гибели клеток и выходе большого количества ферментов, показатели биохимического исследования изменяются, они могут быть превышены в десятки раз в зависимости от вида патологии и размера дефекта.
Аланинаминотрансфераза (АЛТ, АлАТ) – внутриклеточный фермент, участвующий в метаболизме заменимой аминокислоты аланина. Такое вещество как аланин в больших концентрациях содержится в гепатоцитах – структурных клетках печени, в меньших концентрациях их можно обнаружить в клетках миокарда и почечной ткани.
Аспартатаминотрансфераза (АСТ, АсАТ) – фермент, локализующийся в комплексе Гольджи и митохондриях, принимающий участие в расщеплении заменимой аминоклислоты – аспарагина, путем гидролиза амидной группы, образуя оксалоацетат, участвующий в цикле Кребса. Преобладает эта аминотрансфераза в клетках миокарда, печени – гепатоцитах, центральной нервной системы.

АСТ – показатель нарушений в работе сердечной мышцы. АЛТ – печеночно-клеточный фермент, который говорит о нарушении работы гепатоцитов и гепато-билиарного тракта в общем.
Представленные разновидности анализов назначаются в следующих ситуациях:
- желтуха (желтушное окрашивание склер, слизистых, кожных покровов);
- диспепсия (тошнота, рвота, нарушение стула);
- обесцвечивание кала;
- потемнение мочи;
- появление белой пены на моче;
- боли в правом подреберье;
- кожный зуд;
- появление сосудистых звездочек на коже;
- выпадение волос, ломкость, тусклость волос;
- «печеночные ладони» – ярко-желтое, медное окрашивание кожи ладоней и подошв;
- появление несвойственного неприятного запаха «печеных яблок».
Подготовка к анализу
При подготовке к сдаче анализа выполнить следующие манипуляции:
- за 3 суток до предполагаемого исследования следует отказаться от употребления алкоголя и сигарет;
- за 2 дня до сдачи крови воздержаться от употребления в пищу жирных и жареных блюд;
- предупредить лечащего врача обо всех препаратах, которые принимались в последние 10 дней, по возможности отменить прием препаратов за 10 суток до сдачи крови;
- уменьшить физическую нагрузку за неделю до сдачи анализа;
- последний прием пищи должен быть не позднее 19:00 (легкий ужин);
- утром разрешается выпить стакан воды и почистить зубы.
Процесс сдачи
Кровь, для определения уровня данных показателей берут рано утром, натощак, из вены. Результаты должны быть готовы уже на следующий день.

Расшифровка результатов
При расшифровке результатов нужно ориентироваться на представленные в таблице данные.
| Превышение АЛТ до 20 раз АСТ до 4 раз | Острый гепатит, цирроз в стадии распада, острая алкогольная интоксикация |
| Превышение АЛТ в 4 раза АСТ в 10 раз | Острый инфаркт миокарда |
| АСТ превышает норму в 2 и более раз | Миокардит или миозит |
| АЛТ + свободный билирубин | Другая патология печени (фиброз, холангит, холецистит), острый панкреатит |
Определяется и степень активности гепатита.
| Минимальная | увеличение показателей до 3 норм |
| Слабовыраженная | от 3 до 5 норм |
| Умеренно выраженная | от 5 до 10 норм |
| Резко выраженная | ≥ 10 норм |
В случае выполнения АЛТ и АСТ, при гепатите в острой форме, можно определить к какой именно группе он относится:
- острый вирусный гепатит А (тяжелая клиническая форма) – увеличение показателей до 2000-3000 Ме/л;
- острый вирусный гепатит B (умеренно выраженная степень активности) – увеличение показателей до 500 Ме/л;
- острый гепатит С (бессимптомное течение) – показатели трансаминаз в пределах 200 Ме/л;
- алкогольный гепатит (стертое течение) – до 150-180 Ме/л.
- Соотношение АСТ к АЛТ – носит название коэффициента де Ритиса и составляет АСТ/АЛТ = 1,33±0,42.
- Выделяют следующие показатели:
- >2 – означает поражение кардиомиоцитов; самая частая причина – острый инфаркт миокарда, некроз сердечной стенки;
- 1
Жировой гепатоз KDR ≥2 Инфаркт миокарда KDR >1.8 Миокардит Дифференциальный диагноз хронических гепатитов
Гепатит В Гепатит С Мужчины Женщины Мужчины Женщины Возраст До 30 До 30 АЛТ Ед/л 88,0 112,0 102,0 102,0 Возраст До 60 До 60 АЛТ Ед/л 91,0 96,0 99,0 96,0 Возраст Старше 60 Старше 60 АЛТ Ед/л 88,0 74,0 90,0 92,0 Нормальные показатели
Выделяют следующие показатели нормы анализов в зависимости от возраста.
АЛТ(Ед/л) АЛС(Ед/л) до 1 месяца 38,0 32,0 1-12 месяцев 27,0 36,0 1-14 лет 20,0 34,0 15-18 лет 22,0 31,0 Мужчины 18,0 22,0 Женщины 15,0 17,0 Причины отклонений
Снижение показателей может быть спровоцировано следующими патологиями:
- Гепатиты. Острые вирусные (герпесвирусный, цитомегаловирусный, А, В, С, Е). Хронические вирусные(В, С, ко- и суперинфекция гепатита Д). Токсический, алкогольный, лекарственный, ятрогенный. Аутоиммунный. Стеатогепатит.
- Онкологические заболевания печени (первичный, вторичный узловой рак, лейомиосаркома, фибросаркома печени).
- Цирроз и фиброз печени.
- Холангит, холестаз, холедохолитиаз, холецистит.
- Гемохроматоз.
- Болезнь Вильсона-Коновалова.
- Алкогольная или наркотическая интоксикация.
- Прием анаболических стероидов.
Повышение показателей АЛТ и АСТ может быть вызвано наличием таких заболеваний:
- острый инфаркт миокарда;
- кардиогенный шок;
- миокардит;
- краш-синдром;
- миозит;
- острый панкреатит.
- Для дальнейшего выбора тактики и дифференциального диагноза необходимы такие показатели биохимического исследования, как щелочная фосфатаза (ЩФ), гамма-глутамилтрансфераза (ГГТ), холестерин общий, ЛПВП (липопротеины высокой плотности), ЛПНП (липопротеины низкой плотности), общий белок, альфа глобулины, гамма глобулины, билирубин конъюгированный, билирубин свободный, белково-осадочные пробы – тимоловая и сулемовая.
- Помимо биохимии необходимо сдать клинический анализ крови (КАК), копрограмму.
Тимоловая проба (проба Маклагана) – реакция взаимодействия реагента тимола с веществами, синтезируемыми печенью (альфа и гамма глобулины, общим белком, липопротеинами). Повышение показателей выше нормы (0-4 ЕДS-H), свидетельствует о нарушении синтетической функции печени.
Сулемовая проба (реакция Таката-Ара) – хлорную ртуть и карбонат натрия добавляют к сыворотке крови, вызывая реакцию флоккуляции. В норме образуется коллоидальный раствор, при патологии – осаждение грубодисперсных частиц.

Важнейшим показателем наличия гепатита является обмен билирубина. В «биохимии» он отражен в виде показателей неконъюгированного, конъюгированного и общего билирубина.
Нормальные значения Патология Общий билирубин 1,7-17,1 18,0-35,5 Прямой билирубин до 3,5 3,6-15,2 Непрямой билирубин 1,7-12,7 12,8-86,7 Билирубин мочи и уробилин – ++ Стеркобилин + – У детей показатели билирубина несколько отличаются от показателей взрослых
Общий Связанный Свободный Новорожденный 23,09 8,72 14,37 2 сутки 54,22 8,72 45,5 4 сутки 90,1 7,87 82,2 6 сутки 69,0 7,72 63,2 9 сутки 53,0 8,72 44,3 Что может исказить результаты исследования
- Полипрагмазия и бесконтрольный прием антибиотиков, противомикотиков, противовирусных средств, препаратов, снижающих уровень глюкозы в плазме крови (сульфонилмочевина), нестероидные противовоспалительные средства (Кеторол, Спазмалгон, Нимесулид, Парацетамол), Гепарин.
- Также влияют на результаты прием в качестве пищевой добавки эхинацеи, недавние операции на сердце, дебют аллергии.
- Не рекомендуется в один день совмещать такие исследования, как:
- флюорография;
- ректороманоскопия;
- УЗИ органов брюшной полости;
- обзорная рентгенография грудной и брюшной полостей;
- введение рентгеноконтрастных веществ и радиоизотопов;
- физиотерапии (электрофорез).
Низкие показатели аминотрансфераз в биохимическом исследовании плазмы крови пациента могут свидетельствовать о дефиците витамина группы В–В6 (пиридоксина). Данный витамин участвует в метаболизме микроэлементов, нейротрансмиттеров, синтезе белка переносчика кислорода – гемоглобина.
Показатели трансаминирования у беременных женщин
Во время беременности потребность во многих нутриентах возрастает в разы, в том числе и в витаминах группы В. Для физиологического формирования билиарного тракта плода пиридоксина требуется в 3 раза больше. Поэтому у беременных, особенно во втором триместре, данные показатели снижены.

Повышение данных показателей часто свидетельствует о развитии тяжелого осложнения течения беременности – гестоза. Это требует срочного обращения к лечащему врачу.
Профилактика патологических сдвигов
Предотвратить отклонения от нормы в описываемых анализах помогут следующие моменты:
- Здоровый образ жизни. Отсутствие вредных привычек (алкоголь, курение), эмоционального перенапряжения.
- Культура полового поведения (минимальное количество половых партнёров, предохранение барьерными средствами контрацепции).
- Поскольку вирусным гепатитом В, С, Д можно заразиться гемоконтактным путем – пользование услугами только проверенных мастеров татуажа, маникюра, пирсинга.
- Ежегодное посещение таких специалистов, как гастроэнтеролог, терапевт, гепатолог, сдача биохимического анализа крови при прохождении профилактического осмотра.
Диета при повышении АЛТ и АСТ
Необходимо воздерживаться от употребления чрезмерно сладких, солёных блюд, от жареного, жирного и копченого.

Приоритет отдается вареному куриному, кроличьему, индюшиному мясу, нежирной говядине, говяжьей печени. В качестве гарнира рекомендуется гречневая крупа, чечевица, фасоль. В качестве перекусов можно использовать грецкие орехи.
Лекарственные средства, улучшающие работу печени
Механизм действия таких препаратов основан на укреплении мембраны клетки – гепатоцита. Они также улучшают функциональные способности трансаминаз.
Среди распространённых препаратов выделяют следующие:
- Эссенциальные фосфолипиды (Эссенциале, Фосфоглив).
- Растительные флавоноиды (Легалон, Карсил).
- Производные аминокислот (Гептор, Гепасол).
- Препараты урсодезоксихолевой кислоты (Урсодекс, Урсо-100).
- Кукурузные рыльца.
- Витамины группы В, Е.
Таким образом, изменение показателей аланинаминотрансферазы и аспартатаминотрансферазы в биохимическом исследовании крови человека может свидетельствовать о множестве разнообразных патологий.
Справиться с их дифференциальной диагностикой по силам лишь высококвалифицированному доктору.
Не стоит заниматься самолечением, при обнаружении повышенных показателей АЛТ и АСТ нужно незамедлительно обратиться к врачу.
Анализ крови, АЛТ, АСТ, билирубин – что такое, и каковы показатели нормы
Заболевания печени – настолько распространенное явление, что они отнесены Всемирной организацией здравоохранения к настоящей медико-социальной проблеме. Большинство из печеночных патологий на начальных этапах развития протекают относительно бессимптомно или имеют сходную клиническую картину.
Важным этапом дифференциальной диагностики и получения информации о состоянии органа считается анализ крови, АЛТ, АСТ, билирубин – что такое эти специфическиетермины обозначают, о чем они свидетельствуют при различных заболеваниях, понятно только гастроэнтерологу и гепатологу. Делать какие-либо выводы на основании цифр, указанных в бланке анализа, не стоит, они несут информацию только в сочетании с другими данными.
Лабораторные анализы в диагностике заболеваний печени
Биологические жидкости в организме осуществляют множество функций – транспортируют полезные соединения к внутренним органам, участвуют в обменных процессах, выводят отходы жизнедеятельности, излишки выработанного секрета и пигментов. Способы получения информации о состоянии открытой системы человеческого тела вариабельны и совершенствуются постоянно, но есть лабораторные анализы, без которых невозможно обойтись при любом заболевании:
- По общему анализу крови (ОАК) можно определить присутствие воспаления, поскольку клетки гуморальной жидкости участвуют в формировании патогенного механизма, призванного ликвидировать негативные трансформации. Развитие воспаления легко обнаруживается по повышенному уровню лейкоцитов, изменившейся в любую сторону скорости оседания эритроцитов, отклонениям от референсной нормы гемоглобина, необходимого для транспортировки кислорода. Но такое исследование только наглядно демонстрирует наличие запуска защитного механизма, не давая указаний на его локализацию и этиологию.
- Общий анализ мочи сдается для определения процентного соотношения выводимых отходов и остатков. В норме почки не только занимаются их удалением через биологическую жидкость, но и возвращают в кровеносное русло необходимые организму соединения. Переизбыток несвойственных физиологическому составу веществ – например, белка, – тоже говорит о патологии, так же, как и видоизменения в цвете, прозрачности, консистенции. Но это тоже – только общая информация, без конкретного адреса.

- Копрограмма позволяет определить степень переваривания пищи, отсутствие билирубиновых фракций, придающих калу специфическую окраску, присутствие паразитарных инвазий.
- Коагулограмма – демонстрирует патологию в деятельности свертывающей системы крови, протромбиновый индекс, вероятные риски тромбоза или кровотечения.
- ИФА – иммуноферментный анализ проводится при подозрении на деятельность в организме патогенного агента, инфекционного или вирусного. В последнее время он не так востребован, как раньше, потому что иммунная система вырабатывает антитела в течение определенного временного периода. Зато полимеразная цепная реакция незаменима при гепатитах, потому что позволяет обнаружить присутствие вируса по малейшему фрагменту, присутствующему в гуморальной жидкости, реплицируя его до узнаваемой цепочки.
- Гормональное исследование дает возможность выявить нарушения выработки гормонов, несущих ответственность за регуляцию важнейших процессов в человеческом теле. Отклонение от нормы свидетельствует о сбоях привычного механизма, следствием которых могут быть и заболевания печени.
- Золотым стандартом диагностики на начальных этапах обследования считаются печеночные пробы. Это информативная триада, состоящая из коагулограммы, биохимического анализа крови и общего анализа мочи. Основанием для назначения печеночных проб всегда становится биохимия крови как предварительный, но обязательный этап, в котором диагноста интересует прежде всего уровень АСТа – аспартатаминотрансферазы (может называться печеночным энзимом или трансферазой, индикаторным ферментом, и в норме практически не присутствует в гуморальной жидкости). Не менее важным считаются и показатели аланинаминотрансферазы – АЛТа, в норме находящейся в клетках печени и почек и практически не попадающей в кровеносное русло.

Трансферазы, присутствующие в крови и обнаруженные при проведении соответствующего исследования – не только основание для назначения печеночных проб. Это наглядное свидетельство того, что в организме происходит клеточная деструкция, которая и обусловила присутствие в гуморальной жидкости индикаторных ферментов. Они выполняют в анализе крови функцию сигнала, природного индикатора.
Повышение их уровня говорит о вымывании из печеночных клеток, а понижение – о присутствии сбоя в гепатобилиарной системе. Кровь, моча и определение свертываемости – вот три информативных исследования, позволяющих с определенной степенью достоверности говорить о заболевании жизненно важного органа. Это и есть основное назначение проводимых печеночных проб.
Важность метода
Расхожее представление о цели назначения ПП – определение состояния печени. Но результаты этого исследования интересуют не только гастроэнтеролога или гепатолога.
Важное значение имеют и другие показатели, и соотношение между уровнями одного и другого фермента.
Для тех, кто спрашивает у врача – анализ крови, АЛТ, АСТ, билирубин – что такое и для чего это требуется при заболеваниях сердечно-сосудистой системы, есть одно объяснение.
Оба индикаторных фермента свидетельствуют о нарушении целостности клеток. Но если АЛТ важна при диагностике заболеваний печени, то АСТ – свидетельство деструкции миокарда. А если изучить другие данные, то чтение анализа становится ключом к разгадке диагностического ребуса.
Доминирующие показатели
Индикаторные ферменты, АЛТ, АСТ и ЛДГ (лактатдегидрогеназа) в биохимическом анализе играют важную роль. ЛДГ отвечает за окисление глюкозы и выработку молочной кислоты.
Его учитывают как общий признак разрушения клеток, потому что в норме он не присутствует, а расщепляется и немедленно выводится.
Любой разрушающий процесс сопровождается появлением лактатдегирогеназы, но происходит он при этом где угодно.

Аланинаминотрансфераза (АЛТ) в понижении или превышении, указывает на нарушения в экзокринной железе, а аспартатаминотрансфераза (АСТ) – на сердечные патологии. Но первый индикаторный фермент может говорить о повреждениях в других паренхиматозных органах – щитовидке, селезенке и даже легких.
Поэтому важным этапом диагностики становится определение соотношения между АЛТ и АСТ.
Самостоятельная расшифровка анализа пациентом не имеет смысла еще и потому, что существуют возрастные нормы, а также показатели для представителей мужского и женского пола, на которые следует ориентироваться. На показатели может влиять прием лекарственных средств, витаминодефицит и болезни других паренхиматозных органов.
Тонкости диагностики по уровню ферментов в биохимическом анализе, что такое означают полученные цифры – все это требует вдумчивого подхода, кропотливого изучения и профессиональных знаний. К тому же – это не единственные данные, которые необходимы для выводов. Изучается уровень щелочной фосфатазы, билирубин, холестерин и альбумины.
Коэффициент де Ритиса
Это важный показатель лабораторной диагностики, названный по фамилии выдающегося итальянского клинициста и исследователя де Ритиса, впервые обратившего внимание на ценность подсчета соотношения количества печеночных ферментов по отношению друг к другу.
Понять, что такое коэффициент де Ритиса, довольно просто: показатель аспартатаминотрансферазы делится на значение аланинаминотрансферазы, если он не соответствует значению референсной нормы. Для этого нужно учитывать половую принадлежность или возраст, если речь идет о ребенке, а значит, знать референсные цифры в конкретном случае.
Например, АСТ у мужчин колеблется в развале от 15 до 31 единицы, а у противоположного пола от 20 до 40. АЛТ для мужского пола считается нормальным, если оно не выходит за рамки 40 ед./л, у женщин этот показатель составляет – до 32 ед./л.
У здорового человека КДР – от 0,91 до 1,75. Но в этом случае (при нормальных показателях уровня индикаторных энзимов), нет необходимости считать соотношение между АСТ и АЛТ.
Оно определяется при их повышении или понижении, а затем снова становится актуальным, когда диагноз выставлен и проводится лечение.

Для приблизительного понимания, что такое коэффициент де Ритиса, достаточно знать, что отношение АСТ к АЛТ больше двух – наглядная манифестация сердечных патологий, разрушения специфических клеток сердца – кардиомиоцитов. Если же значение уравнения АСТ: АЛТ меньше, чем 0,91, то речь идет о гибели печеночных клеток.
Вирусные гепатиты А и В уже на начальной стадии протекания, из-за массовой деструкции гепатоцитов понижают его от 0,83 до 0,55. Значение этого индекса может варьироваться. Многое зависит от характера патологии.
При этом разобраться, что такое развивается в печеночных клетках, можно обладая практическими знаниями о его колебаниях.
Уточнение диагноза с помощью ПП
Внешняя простота расшифровки биохимического анализа крови обманчива, и для того, чтобы понять, что такое показатели АЛТ, АСТ и даже их соотношение друг к другу, недостаточно изучить только цифры в двух строчках лабораторных данных. Их толкование крайне вариабельно, зависит иногда от естественного состояния (беременности, например). О работе печени свидетельствуют и другие строчки в поученном бланке.
ГГТ
Гаммаглутамилтрансфераза, растущая вместе с АЛТ, говорит о заболеваниях билиарного тракта и собственно экзокринной железы.
Но однозначное толкование невозможно, потому что на рост ГГТ влияет сердечная недостаточность, вызванная застойными явлениями и хроническое злоупотребление алкоголем.
Но если гаммаглутамилтрансфераза в норме, а АСТ – повышена, можно предположить и костные патологии.
Билирубин
БАК содержит сразу три строчки, посвященные показателям билирубина, хотя есть и отдельный анализ на фракции специфического фермента, в норме входящего в состав печеночного секрета. Ежедневно распадаясь в колоссальном количестве, эритроциты перерабатываются печенью и селезенкой.
Распад кровяных клеток приводит к появлению железа (оно необходимо организму и снова запускается в природный обменный цикл, а излишний билирубин выводится выделительной системой). При значительной деструкции печеночных клеток выводить билирубин становится сложнее, а распад эритроцитов увеличивает количество отходов, нуждающихся в выведении.

Гемолиз проходит быстрее, если в печени есть воспаление или нарушена функция детоксикации. В норме печень быстро справляется с порошком в виде кристаллов, происходит целый ряд биохимических реакций, свободные фракции билирубина перерабатываются в связанные, которые не обладают токсичностью первичного продукта распада эритроцитов.
Значительное скопление желчного пигмента приводит к развитию желтухи, потому что нарушение обмена выбрасывает его в кровь и в мочу. В результате выводимая жидкость приобретает цвет темного пива, а кал, при нормальном состоянии окрашенный билирубином, наоборот, становится светлым.
Наличие в крови билирубина, который в привычном, физиологическом состоянии там присутствовать не должен, говорит о нарушениях в деятельности печени. В анализе крови указывается не только свободный и связанный билирубин, но и общий. Общий – это показатель присутствия двух видов билирубина, прямого и непрямого.
В нормальном состоянии связанного должно быть 25%, а свободного – 75%. Подсчитав общее количество билирубина, можно выяснить насколько физиологическое содержание двух видов фракций красящего пигмента. Повышение или понижение уровня – свидетельство патологии.
Иногда АЛТ и АСТ повышены, а билирубиновые показатели не заходят за пределы референсной нормы. Что собой представляет это соотношение, определить тоже сложно. Спектр вероятных поводов при этом достаточно широк – от интоксикаций вариабельной этиологии до поражений сердца, печеночных паразитов и опухолей. Это характерно и для вирусных гепатитов, при которых нет желтушного симптома.

Альбумин
У печени множество функций (более 500), и синтез транспортного белка тоже в них входит. По соответствию норме показателя альбумина можно догадаться о функциональности печени, состоянии осмотического давления крови и осуществлении транспорта билирубина или гормонов.
Уровень альбумина может повышаться и при инфекционных заболеваниях, почечных патологиях, нарушениях эндокринной системы. Но в сочетании с другими характеристиками, выявленными при исследовании крови, это может стать важным диагностическим фактором, основанием для предположений, что такое и как лечить в данном конкретном случае.
Для чего проводится БАК
Врач назначает это исследование для того, чтобы составить общее представление о работе внутренних органов.
Этот метод лабораторной диагностики важен при подозрениях на сбои в работе почек и печени, поджелудочной, билиарного тракта (желчного пузыря и желчных протоков).
Профессиональные знания показателей нормы и патологии АЛТ, АСТ, билирубина, холестерина, альбумина дают развернутую картину соответствия метаболизма в физиологическом состоянии и его трансформаций в результате протекающих в организме негативных процессов.
Ведь жизнедеятельность открытой системы, гомеостаз, зависят от того, насколько полноценно происходит обмен белков, жиров и углеводов, витаминов и микроэлементов – составных частей и участников происходящих в организме биохимических процессов.
Полученные данные дают основания для назначения более детальных и целенаправленных исследований, а вся информация служит выставлению правильного диагноза и определению тактики лечения.
https://www.youtube.com/watch?v=1DEXv7XMXqs
Показатели Алт и аст при циррозе печени на ранней стадии
Человеческий организм – ни на секунду не прекращающая работу биохимическая лаборатория. Спим мы или бодрствуем, работаем или отдыхаем – в нем постоянно протекают тысячи биохимических реакций для обеспечения процессов жизнедеятельности.
Врачи научились измерять многие параметры различных реакций, потому что оказалось, многие из них имеют разные значения в здоровом организме и при возникновении заболевания. Более того, зачастую изменения на биохимическом уровне случаются раньше, чем человек начинает чувствовать симптомы недуга.
Уровень развития современной медицины располагает возможностью ранней диагностики. Показатели Алт и аст при циррозе печени на ранней стадии помогают диагностировать это заболевание, а в дальнейшем дают возможность оценить степень декомпенсации или результаты лечения.
Алт и аст при циррозе
Аланинаминотрансфераза и аспартатаминотрансфераза- это ферменты, осуществляющие транспортировку аминогруппы с одной органической кислоты на другую амино и кетокислоты) в присутствии кофермента пиридоксина (витамина В6), что немаловажно в белковом обмене.
Максимальная активность АСТ выражена в сердечной мускулатуре, она в десятки тысяч преобладает над сывороточной. По органам в порядке убывания идут:
- печень;
- мускулатура;
- мозг;
- почки.

АЛТ максимально проявляется активностью в печени. Далее по убывающей:
- поджелудочная железа;
- миокард;
- мускулатура;
- селезенка;
- легочная ткань.
Избирательность по отношению к тканям организма позволяет считать АСТ маркером сердечной патологии, а АЛТ маркером заболеваний печени.
Соотношение показателей АЛТ и АСТ в частности при циррозе печени позволяет судить о глубине повреждения гепатоцитов. АСТ расположена в митохондриях и цитоплазме, АЛТ – в цитоплазме.
Норма АЛТ и АСТ
Для исследования берут венозную кровь. Существует несколько авторских методик определения, но их можно разбить на 2 основные группы:
- спектрофотометрические (основан на оптическом тесте Варбурга);
- колориметрические (основаны на исследовании полученных в результате реакции окрашенных соединений).
В лабораторной диагностике применяются унифицированные методики для того, чтобы избежать разночтений при оценке результатов анализов. Из спектрофотометрических методов рекомендован к применению непрямой оптический тест Варбурга, из колориметрических – метод Райтмана-Френкеля.
Показатели нормы выражаются в наномолях в сутки на литр или МЕ и различны для разных методик.
Тест Варбурга дает такие величины нормы:- АСТ 30 – 340 нмоль/с х л, что соответствует 2 -20 МЕ;
- АЛТ 30 – 420 нмоль/с х л, что соответствует 2 – 25 МЕ.

По методике Райтмана-Френкеля норма:
- АСТ 28 -130 нмоль/с х л или 0,1 – 0,45 нмоль/ч х л или 1,7 – 7,5 МЕ;
- АЛТ 28 -190 нмоль/с х л или 0,1 – 0,68 нмоль/ч х л или 1,7 – 11,3МЕ.
Соотношение АСТ/АЛТ (коэффициент де Ритиса) одинаков – 1,33 с отклонениями 0,4 в обе стороны.
Подготовка к сдаче анализа
Голодный промежуток накануне сдачи анализа должен быть не меньше12 часов. Запрещены даже мелкие перекусы, разрешается пить чистую негазированную воду. За неделю до этого следует прекратить прием алкоголя, а за несколько часов отказаться от курения.
Накануне обследования лучше оградить себя от переживаний, стрессов, переутомлений и излишней физической активности. По возможности прекратить прием таких лекарств, как Аспирин, Парацетамол, Варфарин, Пенициллин, барбитураты, опиаты, пиридоксальфосфат и оральные контрацептивы. При невозможности прекращения приема проинформировать об этом врача, назначившего анализ.

На показатели может повлиять гемолиз (распад эритроцитов) во взятой пробе крови. Но показатель может быть ложно завышен, так как в эритроцитах содержание трансаминаз шестикратно превышает содержание в плазме.
- Женщины должны информировать врача о наличии беременности, так как при физиологически протекающей беременности и при осложнениях (поздний гестоз, эклампсия) показатели могут быть несколько повышены.
Аминотрансферазы и цирроз печени
Для цирроза печени характерно скрытое течение на ранних стадиях заболевания. Первые симптомы имеют достаточно общее значение и легко могут быть привязаны к другим недугам.
Продолжительность выживания от момента постановки диагноза различна в зависимости от этиологической причины, приведшей к циррозу печени и своевременности начала терапии, восстанавливающей и поддерживающей гепатоциты. Вот почему так важно как можно раньше определиться с диагнозом.
Приходится констатировать факт, что ранняя диагностика цирроза печени в большинстве случаев приходится на случайное выявление этой страшной болезни при обследовании по другим поводам или при профилактическом обследовании.
Лабораторная диагностика цирроза печени строится не только на определении аминотрансфераз, дополнительно необходимы другие печеночные пробы, такие как определение щелочной фосфатазы, гаммаглютамилтранспептидаазы, соотношения прямого и непрямого билирубина, тимоловой пробы.
Изменяется соотношение белковых фракций в сторону увеличения гамма-глобулинов и снижения альбуминов. Производятся иммунологические анализы на уровень иммуноглобулинов класса А, М, G. Есть и более сложные анализы, как например определение антимитохондриальных антител, реакция угнетения бластной трансформации лимфоцитов.

Врачи-гепатологи считают, что 100%-ной достоверностью, указывающей не только на наличие цирроза печени, но и на степень компенсации или декомпенсации является биопсия печени. Но для выполнения этой инвазивной процедуры мало одного подозрения, нужны определенные показания.
Именно для того, чтобы удостовериться в том, все ли в порядке с печенью, есть ли необходимость в дальнейшем обследовании необходимы анализы на АЛТ и АСТ. Они не являются специфичными, АЛТ может повышаться и при патологии мышц или при тепловом ударе, но в целом при начальной патологии печени, сопровождающейся разрушением клеток печени, рост АЛТ будет всегда.
Если сравнить повышение АЛТ при остром гепатите, когда до проявления желтухи идет массовая гибель гепатоцитов с выбросом АЛТ в кровь, то повышение АЛТ при циррозе печени в ранних стадиях уступает гепатитам. Оно превышает верхнюю границу нормы в 4 – 5 раз.
При деструкции и некрозе гепатоцитов идет относительно параллельное повышение обеих аминотрансфераз. Это не зависит от причины повреждения гепатоцитов, разница только в количественных выражениях. При отклонениях работы печени в большей степени повышается АЛТ, чем АСТ, а это значит, что коэффициент де Ритиса в начальных стадиях цирроза печени будет снижаться.
Снижение АЛТ в динамике наблюдения за больным циррозом печени указывает на два возможных варианта:
- затухание процесса в результате лечебных мероприятий;
- стремительное разрушение печеночной ткани.
Переход в терминальную стадию сопровождается снижением АЛТ. Это говорит о том, что практически в печени не осталось нормальных печеночных клеток, печеночная ткань замещена нефункциональной соединительной тканью.
Преобладание повышения АСТ над АЛТ с большей вероятностью указывает на инфаркт миокарда. Повышение АСТ в 20 раз, АЛТ в 10 раз наблюдается через несколько часов после сердечной атаки. Коэффициент де Ритиса превышает 1,33. АСТ в максимальном значении определяется через 1 – 1,5 суток, снижается к 3 -7 дню. Повторное повышение указывает на повторный инфаркт.
Расшифровка результатов
Показания Алт и аст при циррозе должны оцениваться специалистом желательно в комплексе с другими результатами обследования и клиническими симптомами. Признаком, указывающим на раннюю стадию цирроза печени при интерпретации результатов является повышение АЛТ, преобладающее над повышением АСТ и снижение коэффициента де Ритиса.

Для дифференциальной диагностики между циррозом и гепатитом следует учитывать тот факт, что уровень активности аминотрансфераз при гепатите намного превышает их активность при циррозе. Не стоит игнорировать инструментальные методы, позволяющие определить площадь поражения.
- Надо заметить, что показатели Алт и аст при циррозе печени не входят в параметры Международного Калькулятора Чайльд-Пью и аналогичных, позволяющих оценить степень компенсации, риск периоперационных осложнений, продолжительность выживания.
Профилактика цирроза печени
Мудрая поговорка гласит:”Кто предупрежден, тот вооружен”. Именно поэтому для лиц из группы риска актуальны следующие рекомендации.
Лица, злоупотребляющие спиртными напитками, перенесшие острый или страдающие хроническим гепатитом, имеющие заболевания желчевыводящих путей, сопровождаемые сужением желчных протоков и застоем желчи, имеющие аутоиммунные гепатиты, страдающие серьезной сердечной патологией, муковисцедоз, галактоземия, болезнь Вильсона входят в группу риска по развитию цирроза.
Достаточно многие пациенты употребляют лекарственные средства, обладающие токсическим действием на печень. К ним относятся изониазид, метотрексат, амиодарон. Ряд агрессивных химических веществ, с которыми работник связан при выполнении профессиональных обязанностей, тоже неблагоприятно влияют на печень и ее функциональные возможности.
Если человека мучают периодически повторяющиеся приступы болей или тяжести в правом подреберье, подташнивания, чувство горечи во рту по утрам, диспепсии и расстройства стула, непереносимость жирной пищи, кожный зуд, особенно усиливающийся в ночное время на фоне повышенной утомляемости, слабости, снижения работоспособности, нарушение менструального цикла и выпадение волос на лобке и в подмышках у женщин, эректильная дисфункция у мужчин, то им всем рекомендуется сдача анализов крови на АЛТ и АСТ каждые полгода.
Простая процедура дает возможность на раннюю диагностику цирроза печени и увеличение продолжительности жизни. Анализ можно сдать на платной и бесплатной основе.
© 2018 – 2019, MedPechen.ru. Все права защищены.
Аст при гепатите с: норма показателей и отклонения от референсных значений

АСТ при гепатите С является важным показателем, определяемым посредством биохимического анализа крови. Его повышенный уровень в сыворотке крови при наличии других симптомов болезни печени позволяет определить степень поражения органа и стадию заболевания, дает возможность проследить динамику лечения. Показатель используют также для оценки функции сердца. Высокие значения могут свидетельствовать о тяжелой степени ишемической болезни сердца, поражениях сердечной мускулатуры.
Для чего определяют показатель АСТ
Аббревиатура «АСТ» представляет собой сокращенное обозначение эндогенного фермента – аспартатаминотрансферазы. Наряду с ферментом АЛТ он участвует в процессе обмена веществ, осуществляя реакции преобразования и транспорт аминокислот. Благодаря этому происходит синтез необходимых организму соединений.
В определенном количестве этот белок содержится в тканях мышц, селезенки, поджелудочной железы, почек, но преобладает в клетках миокарда и печени. У здорового человека в крови присутствует минимальное количество АСТ.
Увеличение уровня фермента свидетельствует о массовой гибели клеток органа, что указывает на наличие серьезной патологии. Это ранний симптом – он диагностируется еще до появления видимых признаков и ухудшения самочувствия.
Серьезное превышение аспартаминотрансферазы наблюдается чаще при болезнях печени и сердца, но может говорить и о других патологиях:
- осложнения гнойных воспалений (флегмона, гангрена);
- доброкачественные новообразования;
- алкогольное, наркотическое отравление;
- тяжелая физическая и умственная нагрузка;
- последствия химиотерапии и приема некоторых лекарственных средств (Аспирин, оральные контрацептивы).
Значения нормальных показателей уровня АСТ зависят от того, каким методом производится биохимический анализ крови в лаборатории. При выдаче результатов на бланке должны быть указаны границы нормы или референсные значения.
Средние значения нормы при определении оптическим методом таковы:
- для мужчин – до 41 ЕД/л;
- для женщин – до 31 ЕД/л;
- для новорожденных – до 75 ЕД/л.
Бессимптомное течение гепатита С сопровождается увеличением показателя до 200 ЕД/л и выше.
При гепатите С количество АСТ превышает норму в 2-4 раза. Это состояние носит название «умеренная гиперферментемия». Превышение показателя в 10 раз и выше (тяжелая гиперферментемия) может свидетельствовать о начавшемся циррозе, сопровождающемся некрозом печеночной ткани.
Снижение активности белка отмечается редко и может говорить о разрывах печеночной ткани, недостатке витамина В6. Низкое значение АСТ отмечается иногда во время беременности.
Как меняется АСТ при гепатите
При гепатите С показатели АСТ характеризуются неравномерным подъемом. Каждый пик свидетельствует о том, что концентрация вируса в крови стала выше – наступила новая фаза заболевания.
Первое увеличение количества фермента в сыворотке происходит через 2-3 недели после заражения – в начале острого периода болезни. Через некоторое время состояние стабилизируется, и показатель становится ниже.
Вторая волна подъема начинается с появлением первых симптомов (примерно 1,5 месяца с момента заражения). Желтушность кожных покровов свидетельствует, что рост концентрации фермента сопровождается повышенным содержанием в крови пигмента билирубина. Безжелтушная форма гепатита диагностируется только по высокому уровню аспартаминотрансферазы.
Подъем уровня АСТ происходит также при обострении хронической формы гепатита. Стабильно высокие значения свидетельствуют о том, что развивается осложнение – цирроз печени, опухоль, некроз печеночных тканей.
На уровень эндогенного фермента в крови оказывают влияние внешние условия, поэтому забор крови на биохимический анализ должен производиться после определенной подготовки. В течение нескольких дней перед обследованием рекомендуется:
- не употреблять алкоголь;
- по возможности отказаться от приема лекарств;
- отложить медицинские процедуры, включая УЗИ, рентген, лечение зубов.
Следует сдавать кровь на анализ утром, строго натощак, хорошо отдохнувшим и выспавшимся.
Соотношение с АЛТ
При диагностике гепатита С учитывают содержание в крови еще одного фермента, относящегося к группе трансаминаз, – АЛТ (аланинаминотрансфераза).
Этот фермент так же, как и аспартаминотрансфераза, синтезируется преимущественно в клетках печени и миокарда. По превышению его уровня судят о наличии патологий этих органов.
Так как преобладает данный фермент в печени, то при гепатите его уровень в сыворотке, по отношению к норме, повышается значительно – в 8-10 раз.
Если показатели АСТ и АЛТ при гепатите выходят за границы нормы, то для более точной диагностики принято учитывать их соотношение. Данный показатель имеет название коэффициент де Ритиса, и в норме он составляет 1,33 ± 0,42.
- Повышение значения АСТ при одновременном повышении коэффициента де Ритиса до 2 и выше говорит о заболеваниях сердца, сопровождающихся разрушением клеток миокарда.
- Повышение показателя АЛТ при одновременном понижении коэффициента Ритиса до 1 и ниже говорит о вирусных и воспалительных заболеваниях печени.
Если вирусный гепатит С сопровождается высоким уровнем обоих ферментов при низком значении коэффициента де Ритиса, то это свидетельствует о неблагоприятном течении болезни и угрозе развития осложнений.
Бывает ли нормальный АСТ при воспалении печени
Гепатит С характеризуется циклическим повышением уровня АСТ, что соответствует увеличению количества вируса в крови и прогрессированию болезни.
В промежуточные периоды активность фермента снижается и может находиться в пределах нормы. При вялотекущем хроническом заболевании его уровень также может достигать нормальных значений.
И напротив, повышенное содержание белка могут провоцировать другие причины:
- прием определенных лекарств (антидепрессанты, оральные контрацептивы, аспирин);
- длительное пребывание в стрессе;
- сильная усталость.
Поэтому обследование печени при гепатите не должно ограничиваться только определением уровня ферментов и их соотношения. Необходима комплексная диагностика: сбор анамнеза, ультразвуковое и магнитно-резонансное обследование печени, анализ крови на наличие маркеров гепатита.
Аланинаминотрансфераза (АЛТ)
[06-003] Аланинаминотрансфераза (АЛТ)
270 руб.
Аланинаминотрансфераза (АЛТ) – фермент, который находится во всех клетках организма, главным образом в печени и почках, меньше его в сердце и мышцах. В норме активность АЛТ в крови очень низкая. При проблемах с печенью фермент высвобождается в кровоток обычно еще до появления таких характерных симптомов, как желтуха. В связи с этим АЛТ часто используется как показатель повреждения печени.
- Синонимы русские
- Глутамат-пируват-трансаминаза, глутамат-пируват-трансаминаза в сыворотке, СГПТ.
- Синонимы английские
- Alanine aminotransferase, Serum glutamic-pyruvic transaminase, SGPT, Alanine transaminase, AST/ALT ratio.
- Метод исследования
- УФ кинетический тест.
- Единицы измерения
- Ед/л (единица на литр).
- Какой биоматериал можно использовать для исследования?
- Венозую, капиллярную кровь.
- Как правильно подготовиться к исследованию?
- Не принимать пищу в течение 12 часов перед анализом.
- Исключить физическое и эмоциональное перенапряжение за 30 минут до исследования.
- Не курить в течение 30 минут до исследования.
Общая информация об исследовании
Аланинаминотрансфераза (АЛТ) – это фермент, который присутствует главным образом в клетках печени и почек и в заметно меньших количествах в клетках сердца и мышц. У здоровых людей активность в крови невелика, норма АЛТ имеет низкие значения.
При поражении клеток ткани печени АЛТ высвобождается в кровоток обычно еще до появления таких характерных симптомов, как желтуха. В связи с этим активность данного фермента используется в качестве показателя повреждений печени.
Вместе с другими исследованиями, выполняющими те же задачи, анализ на АЛТ входит в состав так называемых печеночных проб.
Печень является жизненно важным органом, который расположен в верхней правой части брюшной полости. Она участвует в осуществлении многих важных функций организма – в переработке питательных веществ, производстве желчи, синтезе белков, таких как факторы свертывающей системы крови, а также расщепляет потенциально токсичные соединения до безопасных веществ.
Ряд заболеваний приводит к повреждению клеток печени, что способствует повышению активности АЛТ.
Наиболее часто анализ на АЛТ назначают, чтобы проверить, не повреждена ли печень при гепатите и приеме лекарственных препаратов либо иных веществ, которые являются токсичными для данного органа. Однако АЛТ не всегда отражает только повреждения печени, активность этого фермента может повышаться и при заболеваниях других органов.
АСТ и АЛТ считаются двумя наиболее важными показателями повреждений печени, хотя АЛТ более специфичен, чем АСТ. В некоторых случаях АСТ напрямую сопоставляется с АЛТ и вычисляется их соотношение (АСТ/АЛТ). Оно может использоваться для выявления причин повреждения печени.
Для чего используется исследование?
- Для выявления повреждения ткани печени при вирусных и токсических гепатитах, других заболеваниях. Как правило, тест на АЛТ назначается вместе с анализом на аспартатаминотрансферазу (АСТ).
- Для контроля за эффективностью лечения заболеваний печени.
Когда назначается исследование?
- При симптомах заболеваний печени:
- слабости, утомляемости,
- потере аппетита,
- тошноте, рвоте,
- боли в животе и его вздутии,
- пожелтении кожи и глазных белков,
- моче темного цвета, светлоокрашенном стуле,
- зуде.
- При наличии факторов, повышающих риск болезней печени:
- ранее перенесенном гепатите либо недавнем контакте с гепатитной инфекцией,
- чрезмерном употреблении алкоголя,
- наследственной предрасположенности к заболеваниям печени,
- приеме лекарств, которые могут повреждать печень,
- избыточном весе либо диабете.
- Регулярно в течение всего процесса лечения для определения его эффективности.
Что означают результаты?
Референсные значения (норма АЛТ для мужчин, женщин и детей):
Возраст, пол Референсные значения 0 — 1 год < 56 Ед/л 1 — 4 года < 29 Ед/л 4 — 7 лет < 29 Ед/л 7 — 13 лет < 37 Ед/л 13 — 18 лет < 37 Ед/л > 18 лет мужчины < 41 Ед/л женщины < 33 Ед/л В норме активность АЛТ в крови очень низкая.
Причины повышенной активности АЛТ:
- вирусные инфекции (чрезмерно высокая активность АЛТ – более чем в 10 раз больше нормы – наблюдается, например, при острых гепатитах; при хроническом гепатите оно обычно превышает норму не более чем в 4 раза);
- прием лекарств или иных веществ, которые являются токсичными для печени;
- болезни, замедляющие приток крови к печени (ишемии);
- непроходимость желчных путей, цирроз (обычно в результате хронического гепатита или закупорки желчных путей) и опухоль печени (умеренное повышение АЛТ).
При большинстве заболеваний печени активность АЛТ выше активности АСТ, так что соотношение АСТ/АЛТ будет низким. Однако существует несколько исключений: алкогольный гепатит, цирроз и повреждение мышц.
Важные замечания
- Внутримышечные инъекции, а также интенсивная физическая нагрузка могут повышать активность АЛТ в организме.
- У некоторых пациентов повреждение печени и, как следствие, увеличение активности АЛТ может быть вызвано приемом БАД. Поэтому необходимо информировать лечащего врача не только обо всех принимаемых лекарствах, но и о пищевых добавках. Кроме того, частое употребление фастфуда способно приводить к незначительному повышению активности АЛТ посредством повреждения печени; в случае нормализации питания активность АЛТ возвращается к норме.
- Также рекомендуется
- Кто назначает исследование?
- Врач общей практики, терапевт, гастроэнтеролог, инфекционист, гематолог, эндокринолог, хирург.